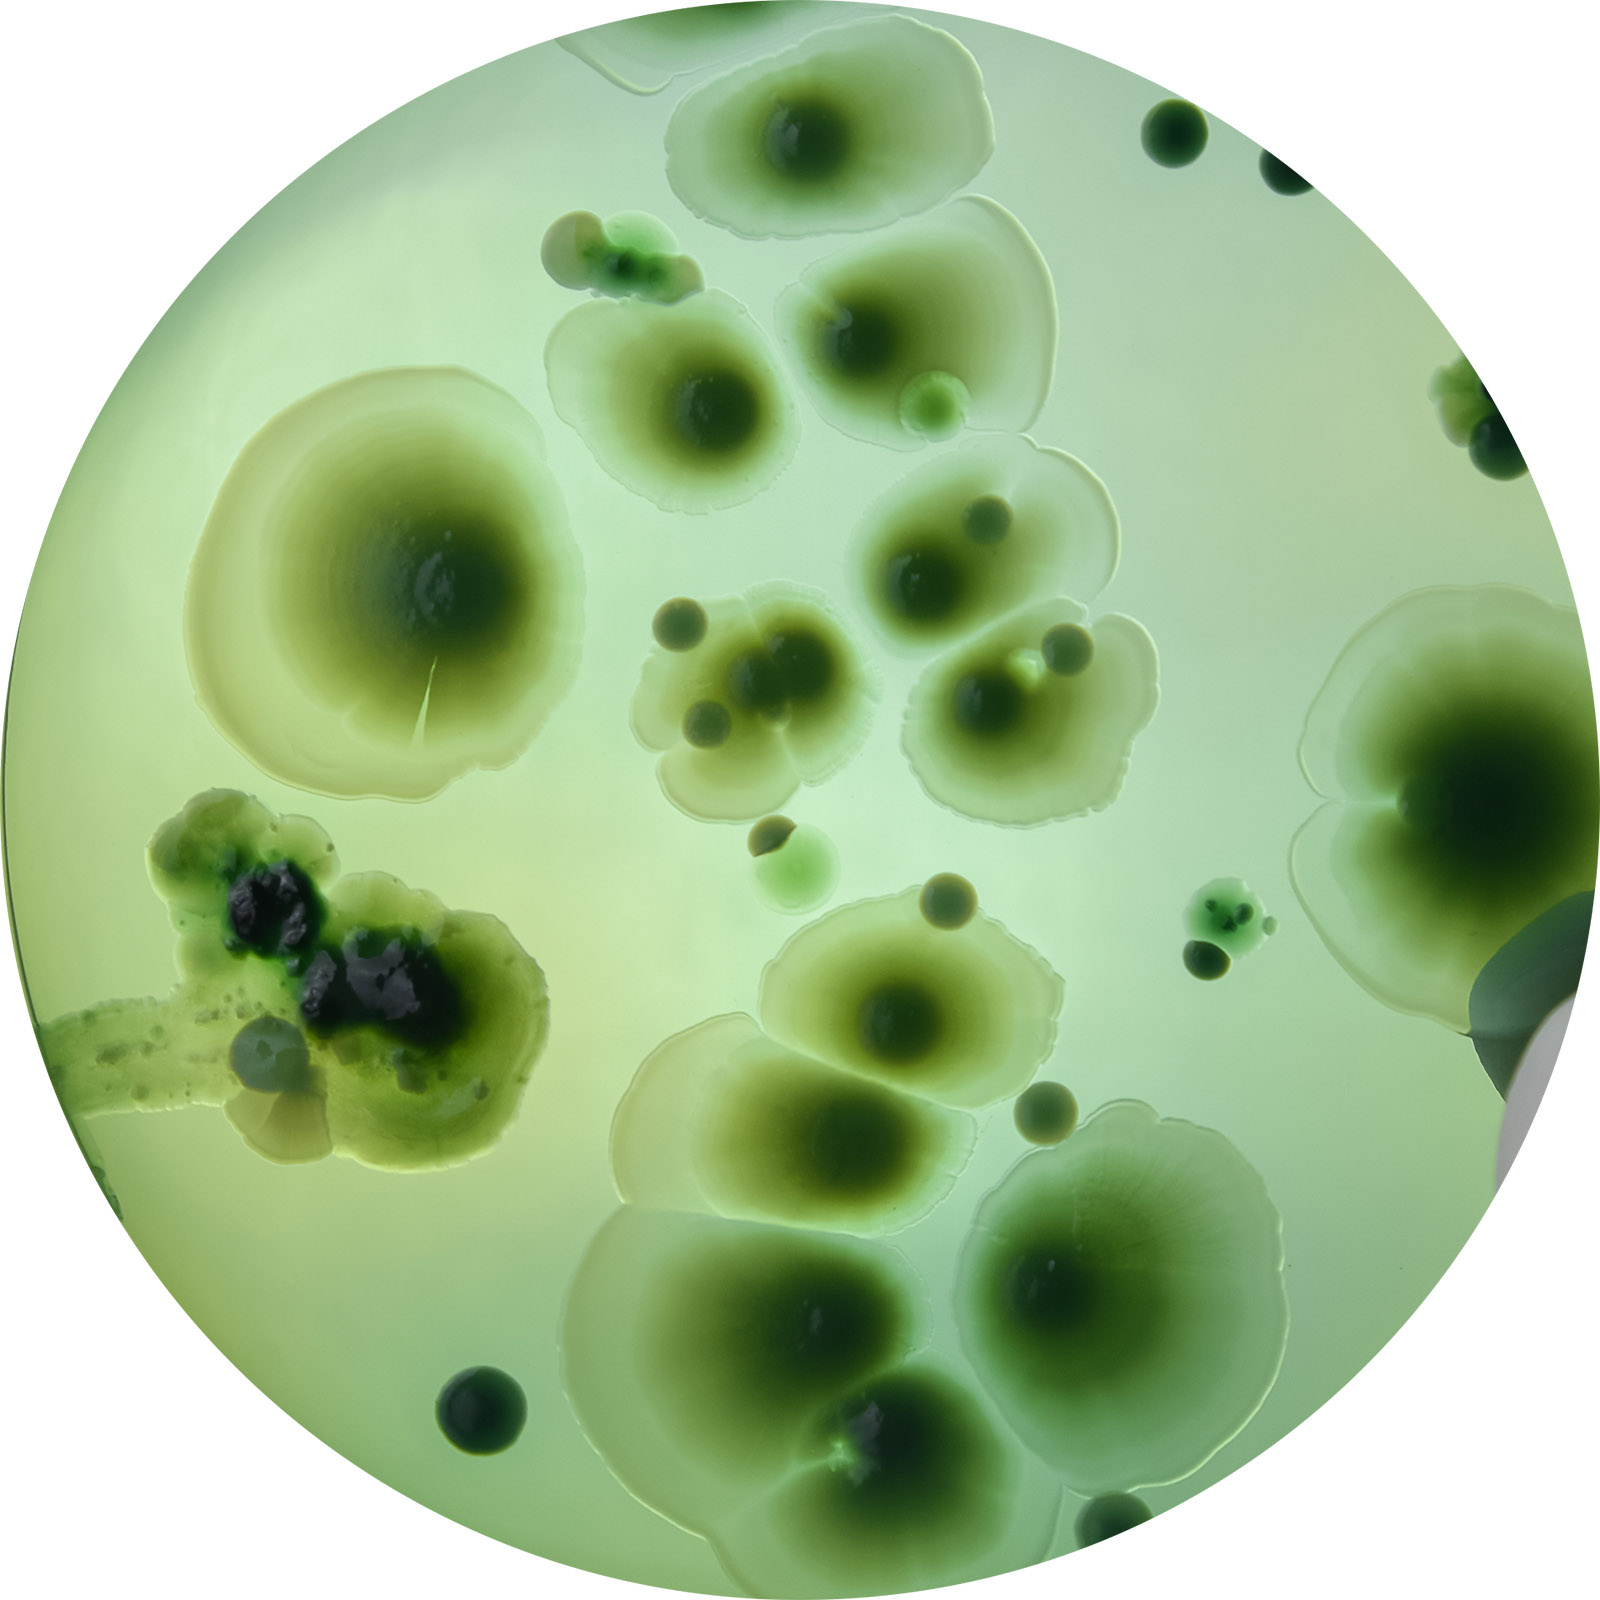

EXO|E™
Discover the power of plant exosomes
Available in sizes:
- 10 Treatment Protocols
- 3 Treatment Protocols
A new approach to your clinical routine with EXO|E™ plant exosome-containing extract
EXO|E™ is a cosmetic range of biomimetic serums that are designed to complement the course of aesthetic procedures to soothe and hydrate the skin. The Revitalizing Complex is a consortia of plant-based secretory factors that correspond to the skin’s needs to restore skin balance. The total solution of EXO|E™ carries the exosomes and other extracellular vesicles.
EXO|E™ Skin Revitalizing Complex is a three-part comprehensive cosmetic program consisting of 29 applications:

Step 1
D|TOX™ Serum
starting with a 7 days pre-treatment protocol
utilizing D|TOX™ (morning & evening)

Step 2
EXO|E™ Serum
a focused in-office EXO|E™ treatment

Step 3
RE|PAIR™ Serum
and a 7 days RE|PAIR™ application for post-treatment (morning & evening)

The proprietary blend of 3 key ingredients:
Ustilago Cynodontis is a fungus with the ability to produce Itaconate acid, which is known for anti-inflammatory properties.1,2

Withania Somnifera Root (Ashwangandha Root) is traditionally used in ayurvedic medicine for its multimodal effects, including anti-inflammatory, anti-oxidative and adaptogenic properties.3

The alkaloid Piperine contributes to the medicinal attributes of Black Pepper, demonstrating anti-inflammatory and anti-oxidative properties.4,5
Application process:

Manufacturing process:
References:
1 Hosseinpour Tehrani H, Saur K, Tharmasothirajan A, Blank LM, Wierckx N. Process engineering of pH tolerant Ustilago cynodontis for effi cient itaconic acid production. Microb Cell Fact. 2019 Dec 12;18(1):213. doi: 10.1186/s12934-019-1266-y. PMID: 31830998; PMCID: PMC6909570.
2 Mills, E. L., Ryan, D. G., Prag, H. A., Dikovskaya, D., Menon, D., Zaslona, Z., Jedrychowski, M. P., Costa, A. S.
3 Narra K, Naik SK, Ghatge AS. A Study of Effi cacy and Safety of Ashwagandha (Withania somnifera) Lotion on Facial Skin in Photoaged Healthy Adults. Cureus. 2023 Mar 15;15(3):e36168. doi: 10.7759/ cureus.36168. PMID: 36937128; PMCID: PMC10017910.
4 Turrini E, Sestili P, Fimognari C. Overview of the Anticancer Potential of the “King of Spices” Piper nigrum and Its Main Constituent Piperine. Toxins (Basel). 2020 Nov 26;12(12):747. doi: 10.3390/ toxins12120747. PMID: 33256185; PMCID: PMC7761056 5 Srinivasan, K. “Antioxidant potential of spices and their active constituents.” Critical reviews in food science and nutrition 54.3 (2014): 352-372
Please note, that the skincare should only be used on fully healed, intact and undamaged skin.
EU responsible person:
CE.way Regulatory Consultants Ltd.
2nd Floor, 13 Upper Baggot St. Dublin, Republic of Ireland



